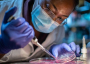
Scientist

World of the Bizarre
November 22, 2020

Image: AI-generated (Midjourney)
In this recent viral video uploaded onto clip-sharing platform TikTok by user Melissa Chipps, one brave man can be seen jumping into a pond to rescue his tiny Cavalier King Charles spaniel after it was snatched by the jaws of an alligator and dragged beneath the water's surface.
Unwilling to allow his beloved canine companion to be swallowed up by the reptile, the man was able to grab hold of the alligator, prize open its mouth and rescue the dog from certain death.
The man - 74-year-old Richard Wilbanks - later revealed that the dog's name was Gunner.
"We were just out walking by the pond," he told CNN. "and it came out of the water like a missile. I never thought an alligator could be that fast. It was so quick."
He explained that the adrenaline had kicked in and without hesitation, he had jumped into the water.
After the incident he had to seek medical treatment and a tetanus shot as his hands were 'chewed up'.
Fortunately Gunner survived the ordeal with only a small puncture wound.
Source: Lad Bible
Man wrestles alligator in bid to save his dog
By T.K. RandallNovember 22, 2020

Image: AI-generated (Midjourney)
A man in Florida was captured on film jumping into a pond to attack an alligator that had grabbed his dog.
Most people are very attached to their dogs, but how many would wrestle an alligator to save them ?In this recent viral video uploaded onto clip-sharing platform TikTok by user Melissa Chipps, one brave man can be seen jumping into a pond to rescue his tiny Cavalier King Charles spaniel after it was snatched by the jaws of an alligator and dragged beneath the water's surface.
Unwilling to allow his beloved canine companion to be swallowed up by the reptile, the man was able to grab hold of the alligator, prize open its mouth and rescue the dog from certain death.
The man - 74-year-old Richard Wilbanks - later revealed that the dog's name was Gunner.
He explained that the adrenaline had kicked in and without hesitation, he had jumped into the water.
After the incident he had to seek medical treatment and a tetanus shot as his hands were 'chewed up'.
Fortunately Gunner survived the ordeal with only a small puncture wound.
Source: Lad Bible

The Unexplained Mysteries
Book of Weird News
AVAILABLE NOW
Take a walk on the weird side with this compilation of some of the weirdest stories ever to grace the pages of a newspaper.
Click here to learn more

Support us on Patreon
BONUS CONTENTFor less than the cost of a cup of coffee, you can gain access to a wide range of exclusive perks including our popular 'Lost Ghost Stories' series.
Click here to learn more
United States and the Americas
Spirituality, Religion and Beliefs
Site News and Announcements
Ancient Mysteries and Alternative History
Total Posts: 7,573,692 Topics: 329,836 Members: 204,502
Not a member yet ? Click here to join - registration is free and only takes a moment!
Not a member yet ? Click here to join - registration is free and only takes a moment!